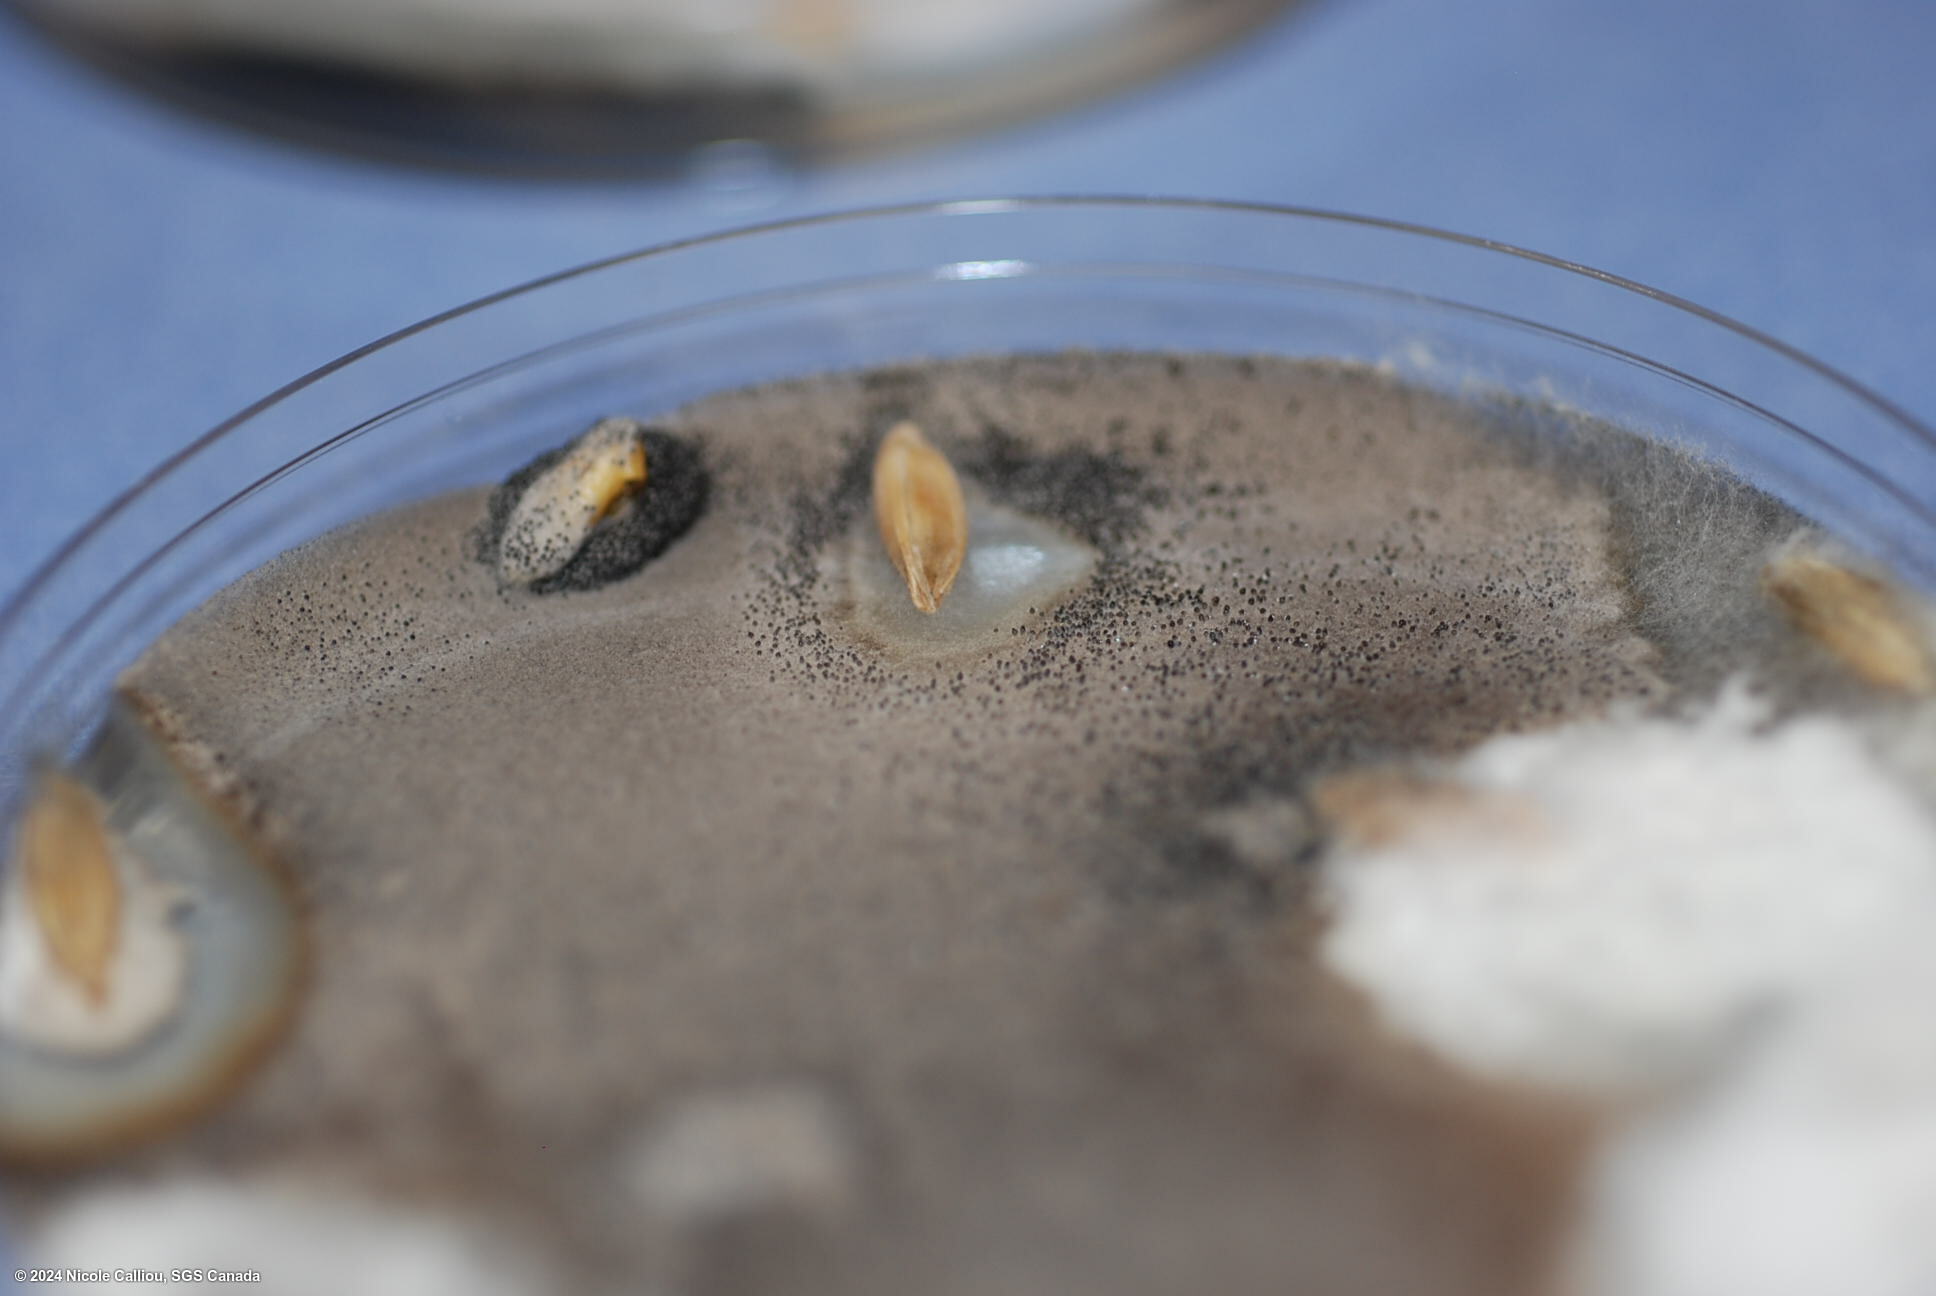
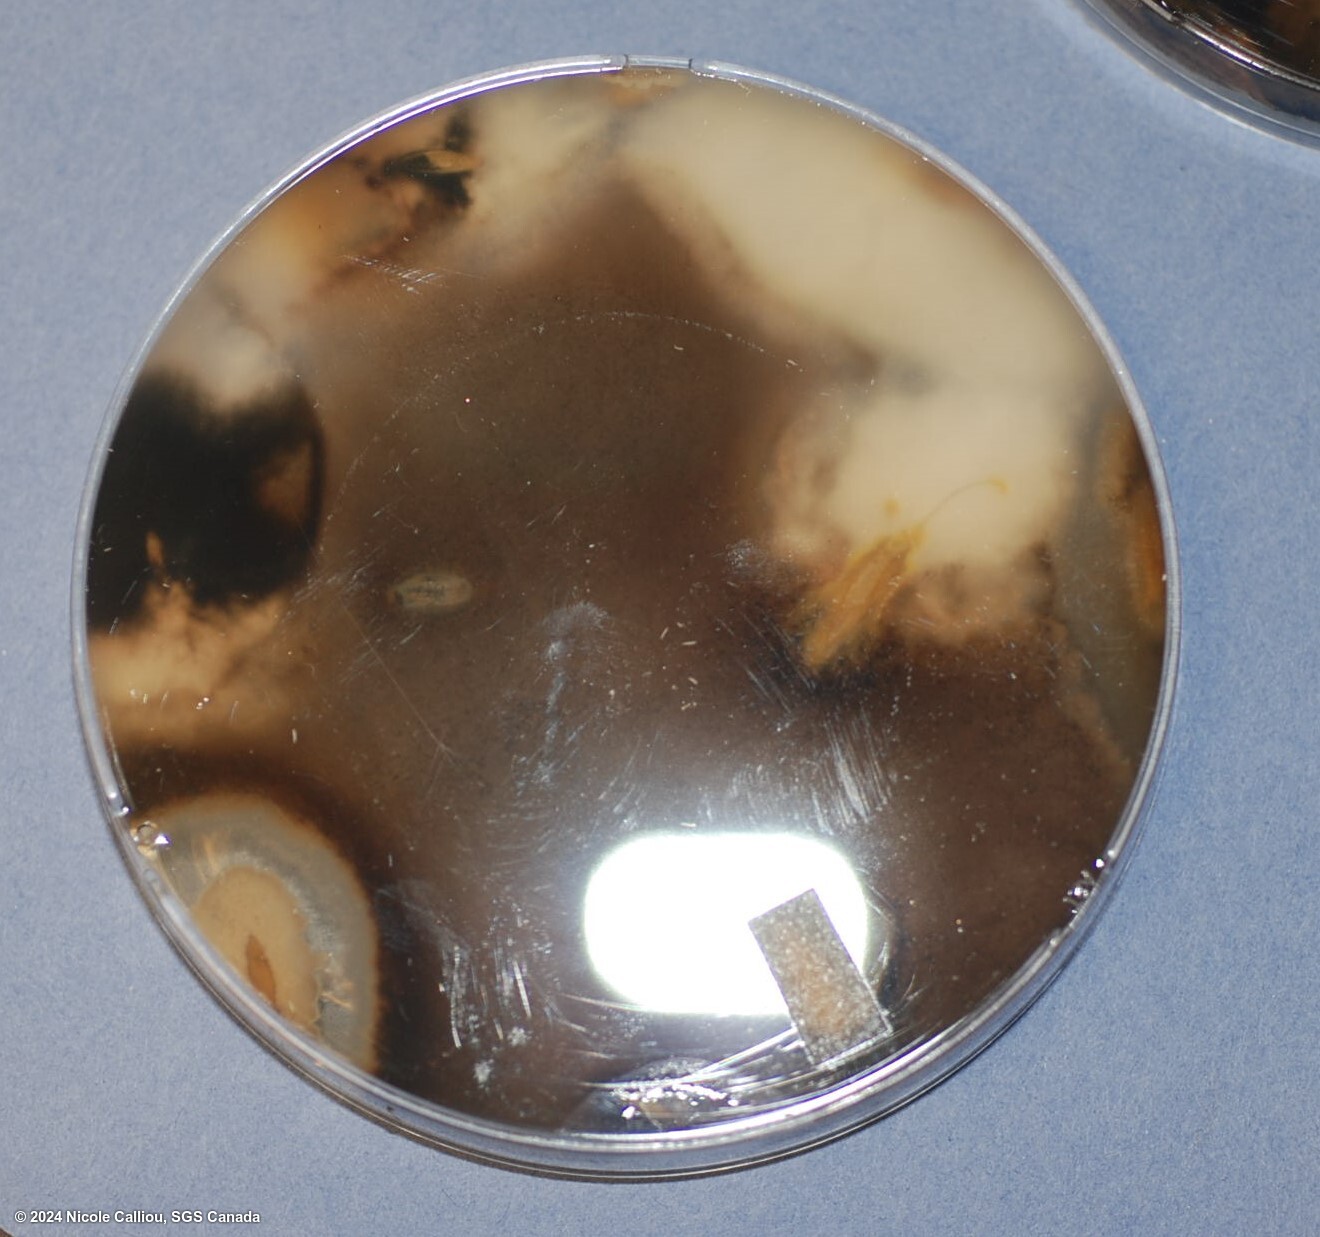

Pathogen
Sordaria fimicola
Overview
|
Scientific name
|
Sordaria fimicola |
|
Genus
|
Sordaria |
|
EPPO code
|
SORDFI |
|
Common name
|
|
|
Synonyms
|
Sphaeria fimicola |
Description
This fungi is not considered to be an important plant pathogen, but rather is considered opportunistic, although some research shows that it can have an inhibitory effect on other pathogenic fungi.
This is a fast growing fungus, with sparse hyphae, and it will produce black perithecia containing asci with eight dark ascospores in a linear arrangement. Common colour mutations are grey or tan.